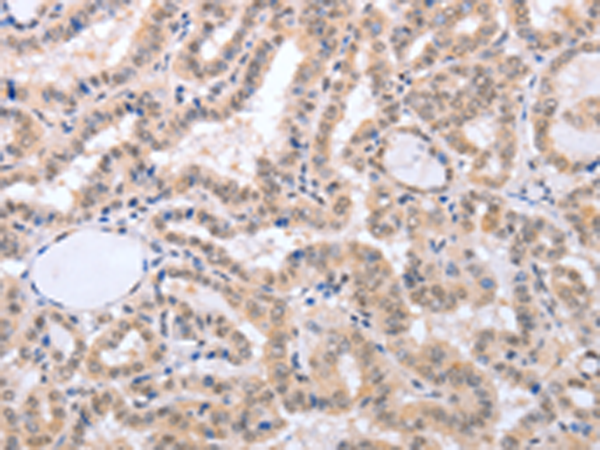

|
Background: |
The protein encoded by this gene is an adaptor molecule that interacts with various cell surface receptors and mediates cell apoptotic signals. Through its C-terminal death domain, this protein can be recruited by TNFRSF6/Fas-receptor, tumor necrosis factor receptor, TNFRSF25, and TNFSF10/TRAIL-receptor, and thus it participates in the death signaling initiated by these receptors. Interaction of this protein with the receptors unmasks the N-terminal effector domain of this protein, which allows it to recruit caspase-8, and thereby activate the cysteine protease cascade. Knockout studies in mice also suggest the importance of this protein in early T cell development. |
|
Applications: |
ELISA, IHC |
|
Name of antibody: |
FADD |
|
Immunogen: |
Fusion protein of human FADD |
|
Full name: |
Fas (TNFRSF6)-associated via death domain |
|
Synonyms: |
GIG3, MORT1 |
|
SwissProt: |
Q13158 |
|
ELISA Recommended dilution: |
1000-5000 |
|
IHC positive control: |
Human thyroid cancer and Human esophagus cancer |
|
IHC Recommend dilution: |
50-150 |
購物車
購物車 幫助
幫助
 021-54845833/15800441009
021-54845833/15800441009
